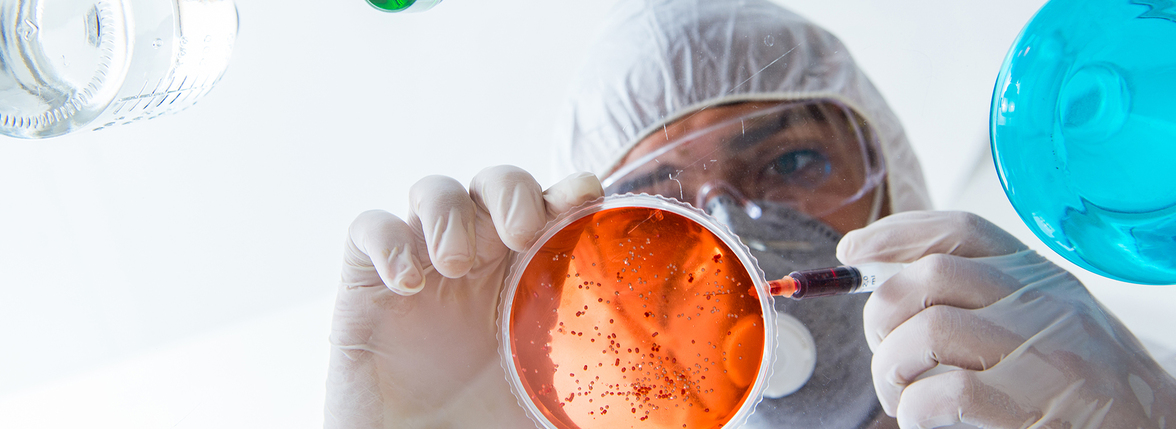
Тенденции в судебной микробиологии: от классических методов к глубинному обучению

Судебная микробиология - это дисциплина, которая занимается изучением микробиологии в контексте судебно-медицинской экспертизы. Ее приложения в основном сосредоточены на диагностике причины смерти, определении места преступления, оценке посмертного интервала (PMI) и идентификации личности.
Многочисленные исследования посвящены использованию микроорганизмов в судебно-медицинской практике. Было доказано, что некоторые специфические микроорганизмы способствуют определению различных причин смерти, включая утопление, отравления и внутрибольничные инфекции.
Учитывая отличительные особенности микробных сообществ в почве, полученной с места преступления и других объектов, микробиом почвы позволяет определить геолокацию. Более того, поскольку микроорганизмы способствуют посмертному разложению, судебно-медицинские исследователи начали изучать возможность использования микробиома для вывода о посмертном интервале в течение последних нескольких лет. Некоторые исследования использовали машинное обучение и другие технологии для создания моделей оценки PMI на основе микроорганизмов, которые действительно повышают точность получения PMI. Кроме того, состав микробиома у людей варьируется в зависимости от расположения тела; характеристик хозяина, таких как пол, возраст и образ жизни; и статуса ухода за кожей. Поэтому индивидуумы могут быть идентифицированы с помощью микробиомов кожи, волос и жидкостей организма.
В этом обзоре рассмотрен прогресс в развитии судебно-медицинской микробиологии от классических до высокопроизводительных методов в сочетании с технологиями искусственного интеллекта и обсуждаются перспективы на будущее.
Судебная микробиология впервые получила глобальное признание в 2001 году в результате атаки на почтовую службу США с использованием спор Bacillus anthracis. В предыдущих исследованиях по судебной микробиологии судебно-микробиологические технологии не были специально описаны, за исключением агаровых сред для бактерий и грибов в сочетании с ПЦР для некоторых микроорганизмов. На сегодняшний день, хотя в хранилищах проекта The Ribosomal Database Project представлено более 2460 различных видов, большинство микроорганизмов окружающей среды не описаны и не доступны для изучения. Лишь немногие их этих бактерий можно культивировать на искусственных средах. Кроме того, традиционная культура микроорганизмов сильно зависит от условий культивирования и имеет ограничения при анализе состава микробных сообществ.
16/18S рРНК является общим маркером для классификации и идентификации микроорганизмов. Флуоресцентная гибридизация in situ (FISH) и денатурирующий градиентный гель-электрофорез (DGGE) используются для обнаружения специфической 16S рРНК и получения доступа к некультивируемым микробам. Технология секвенирования по Сэнгеру, также известная как технология секвенирования первого поколения, позволяет широко использовать секвенирование гена 16S рРНК для таксономии бактерий и приводит к открытию большого количества новых таксонов микроорганизмов.
Технология секвенирования следующего поколения (NGS) позволяет одновременно измерять от десятков тысяч до миллионов ДНК и может обеспечить высокопроизводительную базу данных микробиомов. С развитием технологии секвенирования технология секвенирования третьего поколения имеет больше преимуществ в изучении разнообразия сообществ благодаря сверхдлинному чтению сиквенсов. При этом результаты анализа 16S рРНК собираются в операционные таксономические единицы (OTU). Большинство данных высокопроизводительного секвенирования микробиома не могут быть идентифицированы и классифицированы из-за ограниченности референсных геномов и генетических баз данных. Использование целевой 16S рРНК с короткими амплификаторами не позволило достичь надежного разрешения на уровне видов, а полноразмерные последовательности 16S рРНК не обязательно уменьшают это ограничение. Полногеномное секвенирование (WGS) нацелено на все содержание генов в микробных экосистемах и может дифференцировать микробные виды и таксоны в большей степени, чем ампликоны 16S рРНК.
Хотя возрастающая роль NGS и WGS в сочетании с искусственным интеллектом, вероятно, станет рутинным инструментом в судебной микробиологии, выделение, обнаружение и подтверждение конкретных микробо и использование секвенирования нуклеиновых кислот пока остаются менее актуальными для решения судебно-медицинских задач. Некоторые исследователи предлагают использовать нанотехнологии для разработки биосенсоров для идентификации чужеродных патогенов. Недавно технология компьютерного анализа изображений микроорганизмов в сочетании с машинным обучением и глубинным обучением позволила выявить специфические микробиомы (Ma et al., 2022). Кроме того, при изучении судебной микробиологии сохраняются некоторые проблемы, связанные со стандартизацией, валидацией и биоинформационными процедурами. Дальнейшее развитие технологий будет способствовать совершенствованию применения микробиологии в судебной медицине.
Применение машинного обучения в судебной микробиологии
Создание прогностической модели и предсказание динамической сукцессии микробных сообществ улучшили исследования в судебной микробиологии. Высокопроизводительные микробиотические базы данных в сочетании с машинным обучением расширяют возможности применения микробиомов в судебно-медицинской экспертизе. Традиционные статистические методы могут определить только общий состав микробного сообщества и его основную последовательность, в то время как модели машинного обучения позволяют провести количественный анализ и сделать точный прогноз. В настоящее время различные модели машинного обучения, включая методы случайного леса (RF), опорных векторов (SVM) и AdaBoost, используются в области судебной микробиологии, и они стали перспективной стратегией для нескольких судебно-медицинских экспертиз.
Одним из основных направлений использования судебной микробиологии является идентификация человека. В случаях, когда нет доказательств в виде крови или тканей, микробиологический подход обеспечивает анализ ситуаций с обнаружением микробиома на коже, слюне, волосах или предметах, к которым прикасались. Метрика UniFrac и иерархическая кластеризация используются при определении бактерий, связанных с кожей, и микробиома слюны. В модели RF, использованной для исследования бактерий лобковых волос, точность идентификации индивидуума составила 2,7 ± 5,8%, а точность определения пола - 1,7 ± 5,2%.
Кроме того, машинное обучение может быть использовано для оценки PMI в микробной криминалистике. В 2013 году Metcalf et al. (2013) впервые предложили концепцию "микробных часов" для определения PMI путем создания регрессионных моделей с использованием RF. Кроме того, модели искусственных нейронных сетей (ИНС) используются для определения PMI на основе данных о микробиотических OTU. В 2020 году Liu et al. объединили характеристику микробного сообщества и алгоритмы машинного обучения (RF, SVM и ANN) для изучения закономерностей микробной сукцессии во время разложения трупа и оценки PMI со средней абсолютной ошибкой (MAE) 1,5 ± 0,8 часа в течение 24 часов.
Имеющиеся данные свидетельствуют о том, что судебная микробиология с применением машинного обучения может в определенной степени использоваться для определения геолокации. Микробиота кишечника человека играет важную роль в определении геолокации, что подтверждается корреляциями, основанными на традиционных статистических методах. В 2014 году для анализа микробиома слюны человека были использованы UniFrac и ANOSIM. Дисперсия между индивидуумами составила 6,75-10,21%. В 2020 году Huang et al. применили систему машинного обучения для определения геолокации с точностью 86%.
Как указывалось ранее, машинное обучение может быть использовано для создания моделей идентификации тканей/телесных жидкостей. Lopez et al. (2019) использовали модель ANN для идентификации различных эпителиальных биоматериалов человека со значениями AUC 0,99, 0,99 и 1 для кожи, ротовой и вагинальной секреции соответственно. Позже, в 2020 году, глубинная нейронная сеть (ГНС) была дополнительно использована для успешной идентификации образцов крови человека, имеющих судебно-медицинское значение (Lopez et al., 2020). Текущими проблемами машинного обучения являются недостаточное количество обучающих образцов и несовершенство базы данных микроорганизмов.
Глубинное обучение
По сравнению с машинным обучением, глубинное обучение может реализовать автоматическое изучение признаков благодаря расширенной структуре сети, объединяющей несколько простых модулей. Процесс глубинного обучения обычно требует большого количества обучающих данных, после чего формируются подходящие нейронные сети. Предыдущие исследования доказали, что конволюционные нейронные сети (CNN) и производные от них модели позволяют точно классифицировать тип ткани и идентифицировать микробиом, что может расширить возможности диагностики смерти, вызванной микроорганизмами, и идентификации личности в судебной медицине.
В одном из недавних исследований была построена модель CNN на основе анализа микробиома для классификации трех различных человеческих эпителиальных материалов кожного, орального и вагинального происхождения (Lopez et al., 2019). Другие исследователи предложили и разработали CNN на основе системы для обнаружения грибков, яиц паразитов и бактерий. Точность определения грибов, яиц соевой цистной нематоды и бактерий составила 94,8%, 94,33% и 96% соответственно.
Недавние исследования показали, что модели CNN могут дифференцировать бактерии и водоросли на основе микробиомных изображений. Применение компьютерного анализа изображений микробиома в основном направлено на сегментацию, кластеризацию, классификацию и подсчет микроорганизмов. Модели CNN на основе изображений для идентификации микробиома подтверждаются исследованием (Oomman et al., 2018), в котором удалось обнаружить туберкулез на микроскопических изображениях мазка мокроты с точностью 78,4%.
Кроме того, глубинное обучение анализу изображений в основном сосредоточено на идентификации диатомовых водорослей и водорослей, что могло бы обеспечить потенциальную стратегию для диагностики утопления. В 2018 году Bueno et al. сравнили функции моделей R-CNN и YOLO в обнаружении диатомовых водорослей; F-измерение YOLO составило 84%. В 2019 году Huang et al. применили и обучили модель CNN на основе архитектуры GoogLeNet Inception V3 для идентификации диатомовых водорослей с коэффициентом валидации 97,33%, что указывает на то, что это является эффективной и недорогой технологией автоматического обнаружения диатомовых.
В 2020 году Ruis-Santaquiteria et al. обнаружили, что модели Mask-RCNN и SegNet способны сегментировать диатомовые водоросли из тех же необработанных изображений, которые использовались для ручной идентификации, без какой предварительной обработки. При наличии необходимых операционных систем, таких как Center for Microbial Ecology Image Analysis System (Dazzo and Niccum, 2015), анализ изображений микроорганизмов внесет больший вклад в судебную микробиологию благодаря своему удобству и скорости.
Будущие перспективы
Судебная микробиология все еще находится в процессе становления. Передовые технологии, такие как NGS и WGS, позволили получить такой объем данных, который ранее невозможно было даже представить. Дальнейшее развитие технологий будет продолжать расширять возможности судебно-микробиологических исследований. Кроме того, искусственный интеллект (ИИ) способствовал технологическим инновациям в судебной микробиологии в последние десятилетия. По мере накопления баз данных геномного секвенирования и изображений микроорганизмов глубинное обучение будет оказывать все большее влияние на создание лучших прогностических моделей с более высокой точностью. Однако есть несколько вопросов, которые заслуживают дальнейшего обсуждения.
1. Преимущества и недостатки ИИ
Основываясь на текущей базе данных микробиоты, машинное и глубинное обучения обладают быстрой и автоматической способностью относительно точного прогнозирования по сравнению с традиционными методами. Но "черный ящик" методов ИИ не может полностью и теоретически охарактеризовать реальные результаты. Хотя новые алгоритмы ИИ прольют свет на микробиотический анализ в судебно-медицинских целях, основная стратегия направлена на увеличение базы данных микробиоты для более эффективной работы ИИ.
2. Ключевые моменты для создания баз данных микробиоты для судебной экспертизы
Учитывая вариативность микробных сообществ, создание судебно-медицинского банка микробиоты является насущной необходимостью. Процедуры отбора образцов и секвенирования судебно-медицинских микроорганизмов все еще нуждаются в дальнейшей стандартизации. Кроме того, в связи со сложным влиянием типов образцов, местоположения, факторов окружающей среды и посмертных изменений, следует рассмотреть возможность объединения данных микробиома экспериментальных животных, образцов человека и некоторых материалов с места преступления. Исследователи должны осуществлять многоцентровое сотрудничество.
3. Микробиом в сочетании с другими методами для решения судебно-медицинских проблем
Выделение дифференциальных микробов с помощью биоинформационных технологий могло бы лучше выявлять микробные маркеры. ИИ может создать модели для прогнозирования судебно-медицинских проблем. На основе специфических микроорганизмов, которые могут характеризовать различные биологические жидкости и среды, даже индивидуальную идентификацию, может быть изучено целевое ПЦР-тестирование выбранных микроорганизмов для повышения эффективности и точности решения судебно-медицинских проблем в будущем.